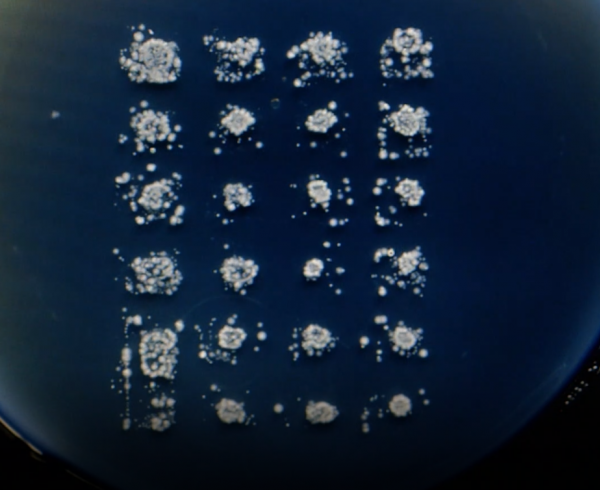

Grand Angle Productions
Ces microbes qui nous gouvernent
Les océans de la surface aux abysses, les sols, les plantes, les intestins d'un insecte ou les organismes des grands mammifères l’Homme compris... Aucun recoin de cette planète n'échappe aux microbes.
Sait-on que sur les millions de milliards de bactéries qui peuplent notre planète, moins de 1% sont pathogènes ?
Les découvertes récentes montrent que les microbes sont non seulement aux origines de la vie sur Terre mais qu’ils sont devenus indispensables à la vie allant jusqu’à être reconnus aujourd’hui comme (co)responsable de notre évolution, et nous invitant même à revisiter l’évolution selon Darwin...
Respirer. Se nourrir et digérer. Grandir. Se protéger. Se reproduire. Pour toutes ces fonctions vitales, l’Homme et plus largement les organismes vivants sur Terre, vivent en symbiose avec les bactéries. Avec le Monde Bactérie, c'est cette nouvelle vision du vivant que nous allons découvrir.
Intervenants :
- Margaret McFall-Ngai, Wisconsin University, USA
- Patrick Forterre, Institut Pasteur, Paris France
- Takema Fukatsu, AIST, Japon
- Marc André Sélosse, Muséum national d'histoire naturelle de Paris, France
- Jeffrey Gordon, Washington University, St. Louis, USA
- Bernard Ollivier, de l’université de Marseille (IRD), France
- Seth Bordenstein, Vanderbilt University, USA
- Sylvain Charlat, CNRS, Lyon
- Nicole Dubilier, de l'Institut Max Planck de Brême, (Allemagne),
- Gérard Eberl, Institut Pasteur, Paris France
- Kevin Theis, Michigan University State, USA
Fiche technique

Réalisateur : Stéphane Bégoin
Producteurs : Grand Angle Productions
Co-producteurs : ARTE
Pays de production : France
Année : 2016
Format : HD
Durée : 54’